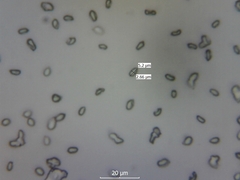
Clitocybe rivulosa

Clitocybe rivulosa: taxon details and analytics
- Domain
- Kingdom
- Fungi
- Phylum
- Basidiomycota
- Class
- Agaricomycetes
- Order
- Agaricales
- Family
- Clitocybaceae
- Genus
- Clitocybe
- Species
- Clitocybe rivulosa
- Scientific Name
- Clitocybe rivulosa
Summary description from Wikipedia:
Clitocybe rivulosa
Clitocybe rivulosa, commonly known as the false champignon or fool's funnel, is a poisonous basidiomycete fungus of the large genus Clitocybe. One of several species similar in appearance, it is a small white funnel-shaped toadstool widely found in lawns, meadows and other grassy areas in Europe and North America. Also known as the sweating mushroom, it derives this name from the symptoms of poisoning (SLUDGE syndrome). It contains potentially deadly levels of muscarine.
...Clitocybe rivulosa in languages:
- Bokmål
- lumsk traktsopp
- Czech
- strmělka odbarvená
- Danish
- Eng-tragthat
- Dutch
- Giftige weidetrechterzwam
- English
- Fool's Funnel
- French
- Clitocybe du bord des routes
- French
- Clitocybe blanchi
- Hebrew
- משפכנית לבנה
- Hungarian
- mezei tölcsérgomba
- Lithuanian
- Nuodingoji tauriabudė
- Russian
- Говорушка красноватая
- Swedish
- gifttrattskivling
Images from inaturalist.org observations:
We recommend you sign up for this excellent, free service.
Parent Taxon
Sibling Taxa
- Clitocybe aeruginosa
- Clitocybe agrestis
- Clitocybe albidula
- Clitocybe albofragrans
- Clitocybe alnetorum
- Clitocybe amarescens
- Clitocybe americana
- Clitocybe angustissima
- Clitocybe anisata
- Clitocybe augeana
- Clitocybe australiana
- Clitocybe barbularum
- Clitocybe brumalis
- Clitocybe brunneocaperata
- Clitocybe brunneocephala
- Clitocybe brunneoceracea
- Clitocybe cacabus
- Clitocybe californiensis
- Clitocybe cistophila
- Clitocybe coacta
- Clitocybe concava
- Clitocybe coniferophila
- Clitocybe connexa
- Clitocybe crispa
- Clitocybe dealbata
- Clitocybe deceptiva
- Clitocybe diatreta
- Clitocybe dilatata
- Clitocybe diosma
- Clitocybe ditopa
- Clitocybe dryadicola
- Clitocybe eccentrica
- Clitocybe elegantula
- Clitocybe erubescens
- Clitocybe favrei
- Clitocybe festiva
- Clitocybe flavidella
- Clitocybe formosa
- Clitocybe fragrans
- Clitocybe frysica
- Clitocybe fuligineipes
- Clitocybe fuscosquamula
- Clitocybe glacialis
- Clitocybe glaucoalba
- Clitocybe gracilis
- Clitocybe griseifolia
- Clitocybe hydrogramma
- Clitocybe hydrophora
- Clitocybe idahoensis
- Clitocybe inflatipes
- Clitocybe infundibuliformis
- Clitocybe lazulina
- Clitocybe leucodiatreta
- Clitocybe lituus
- Clitocybe marginella
- Clitocybe metachroa
- Clitocybe mexicana
- Clitocybe mitis
- Clitocybe nebularis
- Clitocybe nitrophila
- Clitocybe odora
- Clitocybe olivaceobrunnea
- Clitocybe ornamentalis
- Clitocybe paraditopa
- Clitocybe patelliformis
- Clitocybe pausiaca
- Clitocybe peralbida
- Clitocybe phyllophila
- Clitocybe pinophila
- Clitocybe plana
- Clitocybe pleurotus
- Clitocybe praemagna
- Clitocybe pseudoobbata
- Clitocybe regularis
- Clitocybe rivulosa
- Clitocybe robusta
- Clitocybe salmonilamella
- Clitocybe segeolens
- Clitocybe semiocculta
- Clitocybe senilis
- Clitocybe strigosa
- Clitocybe suaveolens
- Clitocybe subalutacea
- Clitocybe subclavipes
- Clitocybe subcordispora
- Clitocybe subditopoda
- Clitocybe subspadicea
- Clitocybe thujana
- Clitocybe tornata
- Clitocybe toxica
- Clitocybe truncicola
- Clitocybe tuba
- Clitocybe umbilicata
- Clitocybe vibecina
- Clitocybe wellingtonensis